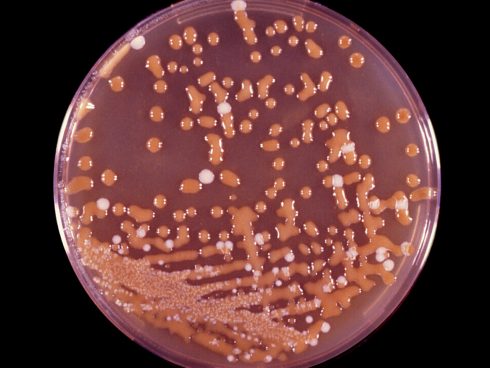
آگار Bird Seed

مقدمهای بر آگار Bird Seed
آگار Bird Seed یک محیط جامد است که برای جداسازی انتخابی و افتراقی کریپتوکوکوس نئوفرمانس از نمونههای بالینی استفاده میشود. کریپتوکوکوس نئوفرمانس یک مخمر محصور شده است که آنزیم فنولاکسیداز را تولید میکند، آنزیمی که برای سنتز ملانین ضروری است. کلنیهای رنگدانه قهوهای Cryptococcus neoformans در سال 1962 توسط Staib هنگامی که کشت مخمر را روی محیطهای حاوی دانههای Guizotia abyssinica انجام میداد، مشاهده شد.
بعدها مشخص شد که دانهها حاوی اسید کافئیک هستند که به عنوان بستر تولید ملانین عمل میکند. در سال ۱۹۶۶، Shields و Ajello، Staib’s آگار Bird Seed (محیط مورد استفاده توسط Staib) را با افزودن عوامل ضد میکروبی اصلاح کردند. این محیط همچنین به نامهای کافئیک اسید آگار یا نایجر سید آگار یا استیب آگار نیز شناخته میشود.
ترکیبات آگار Bird Seed

مواد افزودنی به هر بطری ۵۰۰ میلیلیتری:
- پنیسیلین G (20 واحد در میلی لیتر) = ۰٫۵ میلی لیتر
- جنتامایسین (۴۰ میلی گرم در میلی لیتر) = ۰٫۵ میلی لیتر
اساس آگار Bird Seed
عصاره دانههای Guizotia abyssinica حاوی اسید کافئیک است که به عنوان بستری برای تشخیص فنول اکسیداز، آنزیمی که توسط C. neoformans تولید میشود، عمل میکند. اثر فنول اکسیداز بر روی اسید کافئیک منجر به تولید ملانین میشود که توسط دیواره سلولی مخمر جذب میشود و رنگدانههای قهوهای مایل به قرمز را تشکیل میدهد. گلوکز منبع انرژی در محیط است. کراتینین باعث افزایش ملانیزاسیون برخی از سویههای C. neoformans میشود. آگار عامل انجماد است.
موارد استفاده از آگار Bird Seed
برای جداسازی و تمایز انتخابی Cryptococcus neoformans از سایر مخمرها استفاده میشود.
تهیه آگار Bird Seed
- دانههای آسیاب شده گیاه Guizotia abyssinica را با 1000 میلی لیتر آب مقطر مخلوط کنید.
- ترکیب حاصل را ۳۰ دقیقه بجوشانید، از کاغذ صافی رد کنید و حجم را به ۱۰۰۰ میلی لیتر تنظیم کنید.
- بقیه مواد را اضافه کنید تا صاف و حل شود.
- در دمای ۱۱۰ درجه سانتیگراد به مدت ۱۵-۲۰ دقیقه اتوکلاو کنید.
- تا دمای ۴۸ درجه سانتیگراد خنک کنید و ۰٫۵ میلی لیتر پنیسیلین G و ۰٫۵ میلی لیتر جنتامایسین را به هر ۵۰۰ میلی لیتر آگار دانه پرنده اضافه کنید.
- سپس به آرامی مخلوط کرده و در پتری دیشها بریزید.
تفسیر نتایج در مورد آگار Bird Seed
مثبت: ایجاد کلنیهای صاف دارای رنگدانه قهوهای تا سیاه.
مثالی از موارد مثبت: کریپتوکوکوس نئوفورمان/ Cryptococcus neoformans
منفی: کلونیهای بدون رنگدانه
مثالهایی از موارد منفی: کریپتوکوکوس لورنتی/، ساکارومایسس سرویزیه، E. coli و غیره.
کنترل کیفیت در آگار Bird Seed
کنترل مثبت: کریپتوکوکوس نئوفورمان ATCC 32045، رشد ؛ کلنیهای رنگدانهای قهوهای تا سیاه
کنترل منفی: اشریشیا کلی ATCC 25922، مهار جزئی تا کامل
محدودیتهای آگار Bird Seed
- سویههای نادر نئوفورمانها ممکن است کلنیهای رنگدانهای تولید نکنند.
- نمونههایی که بهشدت آلوده به باکتری هستند ممکن است رشد و یا رنگدانه نئوفورمانها را پنهان کنند.
- Aureobasidium، Sporothrix، Wangiella و Phialophora ممکن است کلنیهای قهوهای تیره ایجاد کنند، اما این رنگدانه، نتیجه فعالیت آنزیمی شناخته شده که باعث ایجاد رنگدانه مدنظر در محیطهای کشت میشود، نیست.
جهت خرید و یا استعلام قیمت با ما تماس بگیرید یا در واتسپ پیام بزارید
مطالعه بیشتر:
- تست کلیگر آیرون آگار (تست KIA): اساس، محیط کشت، روش، نتایج، موارد استفاده
- آگار ستریماید (Cetrimide Agar): ترکیب، اساس، کاربردها، آماده سازی و مورفولوژی کلنی
مترجم: مریم محجوب



